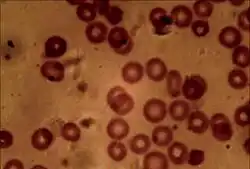

Wikijunior:Human Body/Blood
Blood is vital for the human body. Without it, none of the other organs or cells of the body could function.
What does blood look like?
Blood is a liquid. In humans, as with many other animals, oxygenated blood (the blood that is carrying a lot of oxygen) is bright red. De-oxygenated blood (the blood that has given away most of its oxygen) is a darker shade of red. It is often thought that the blood in veins is blue, but this is not true. It only looks blue through the skin because of the way light moves through the skin.
What are the parts of the blood?
Blood is made up of many different things, red blood cells, white blood cells, platelets, and plasma. These three types of cell are very important and keep the other cells of the body alive and healthy. Also blood is used to send signals in the body since every cell can be reached this way. For example, the hormone (a small signalling molecule) insulin tells cells that food is on the way and cells should take up nutrients from the blood. This is the way of cells send each other instructions.
The red blood cells carry gases such as oxygen that are needed for cellular respiration.
The white blood cells are part of the immune system and play an active role in fighting infections in the body.
The platelets help the blood clot or stick together. If you get a cut or scrape, this helps stop the bleeding. The platelets create a 'mesh' that the red blood cells can clot upon. This prevents the body from losing more blood and helps to keep infection from entering the body.
The blood plasma is an aqueous substance made up of about 92% water, 8% blood proteins and small traces of other substances including:
- Antibodies (for fighting off infections)
- Hormones (chemical messengers used to control many of the body's functions)
- Oxygen (transporting it to other cells)
- Glucose and fats (to feed the body's cells)
- Carbon dioxide (removed from other cells)
- Salts (for maintaining the correct levels of ions in and around cells; when salts dissolve in water, they turn into ions)
What is the function of the blood?
In the human body, blood is the transport system. It allows the body to bring essential things such as nutrients and oxygen from central locations (i.e. The lungs or small intestine) to every part of the body. Blood is circulated all the way around the body many times a minute. It is pumped by the heart.
Transport of Oxygen
One of the most important things that the blood does is to carry oxygen from the lungs to the cells of the body. It is carried inside the red blood cells by a chemical called haemoglobin.
Transport of Carbon Dioxide
As cells function, they produce carbon dioxide. If this is left in the cells, they become useless. Fortunately, the blood removes the carbon dioxide from the cells and takes it to the lungs where it can be breathed out of the body.
Controlling Body Temperature
The blood is also used to control the temperature of the body. If the body becomes hot (during the summer for example), more blood will flow to the surface of the skin. This cools the body. If the body becomes cold, the blood will be forced to flow deeper inside the body, keeping the body warmer.
How does the blood interact with other parts of the body?
Blood is produced in the bone marrow (inside bones). It also gets parts from the liver and kidneys among other body parts.
Blood is pumped throughout the body by the heart. Blood gets oxygen from the respiratory system and nutrients from the digestive system. Blood flows through the kidneys to be cleaned.
When the blood cells have reached the end of their useful lives, they are broken down in the liver and then put into the urine by the kidneys to get rid of non-reusable parts. The reusable parts, such as protein and iron, are recycled by the liver.